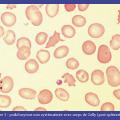

Hydrocéphalie non communicante
HYDROCEPHALIE
Image
Épanchement pleural droit, ostéolyse vertébrale, abcès prévertébral
EPANCHEMENT PLEURAL
OSTEOLYSE
ABCES
Image
Omarthrose excentrée
ARTHROSE
EPAULE
Image
Radiographie du bassin
HANCHE
BASSIN
Image
Poïkilocytose non systématisée avec corps de Jolly (post-splénectomie)
ERYTHROCYTES ANORMAUX
Image
Syphilis secondaire – 1re floraison
SYPHILIS
EXANTHEME SUBIT
Image
Larva migrans cutanée
LARVA MIGRANS
Image
Larva migrans cutanée
LARVA MIGRANS
Image
Carcinome épidermoïde de l'oreille
CARCINOME EPIDERMOIDE
Image
Chancre syphilitique
SYPHILIS CUTANEES
PENIS
Image
Bartholinite aiguë
MALADIES DE LA VULVE
Image
Mycose du pied
TEIGNE
PIED D'ATHLETE
MYCOSE
Image
Lésions de type morsure
ENFANT
VIOLENCE DOMESTIQUE
Image
Lésions de prise d’aspect digitiforme chez un nourrisson de 1 mois
ENFANT
VIOLENCE DOMESTIQUE
Image
Sillon scabieux au dermoscope
GALE
SARCOPTE SCABIEI
DERMOSCOPIE
Image
ECG
ECG
ELECTROCARDIOGRAPHIE
ELECTROCARDIOGRAMME
Image
Syphilides
SYPHILIS
SYPHILIS CUTANEE
EXANTHEME
Image
Lancaster avec paralysie oculo-motrice du III droit
OPHTALMOPLEGIE
Image
Apoplexie pituitaire (IRM cérébrale, coupe coronale)
APOPLEXIE HYPOPHYSAIRE
SINUS CAVERNEUX
IMAGERIE PAR RESONANCE MAGNETIQUE
Image
Métastases hépatiques (IRM)
TUMEURS COLORECTALES
METASTASE TUMORALE
Image
Radiographie thoracique normale
RADIOGRAPHIE THORACIQUE
Image
Hémorragie intra-alvéolaire
HEMORRAGIE
ALVEOLES PULMONAIRES
Image
Différents aspects et causes des onycholyses
ONYCHOPATHIES
ONGLES
Image
Condylomes
CONDYLOMES ACUMINES
INFECTIONS A PAPILLOMAVIRUS
Image
Condylomes
CONDYLOMES ACUMINES
INFECTIONS A PAPILLOMAVIRUS
Image